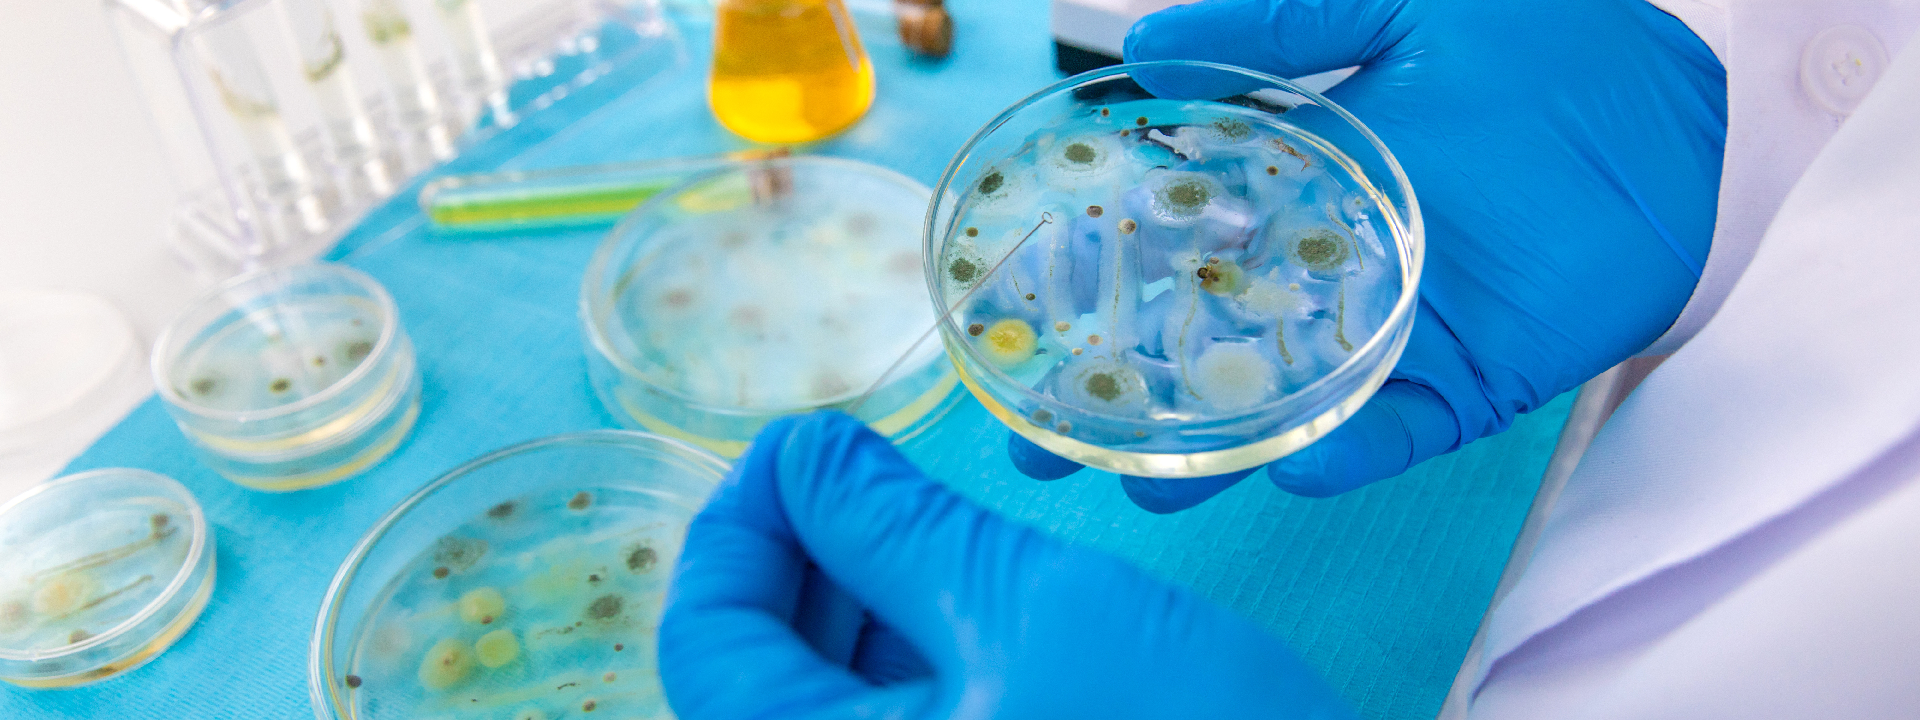

‹
›
01
02
03
04
Chemical, Microbiological & Cosmetics Testing Lab
Trusted Industry-Leading

OUR SERVICES
Precision Testing
Precision Testing
& Analytical Expertise
Delivering advanced chemical, microbiological, and cosmetic testing solutions with accuracy, reliability, and industry compliance.
- Extractable & leachable studies
- Elemental Impurities
- Raw Materials And Excipient Testing
- Microbiological Testing
- Probiotic Assay
- Nitrosamines Impurities
- Impurity Identification
- Research & Development
- Deformulation And Reverse Engineering
- Enzyme Activity Assay
- Laboratory Testing Services
- Gas Chromatography
- Routine Testing
- Stability Storage and Testing Program
- Botanical ID by HPTLC
- Amazon’s Certification Requirements
31+
Years of Experience
200+
Happy Customers
100%
Customer Satisfaction
WE ARE CHROMAK
Chromak Research Laboratory was established in 1986. From our beginnings in 1986, we have steadily grown into our role as the industry leader. We have done this through continual improvement and innovation and through supporting our customers’ operations by reducing risk and improving productivity.

Facebook
Facebook
 LinkedIn
LinkedIn